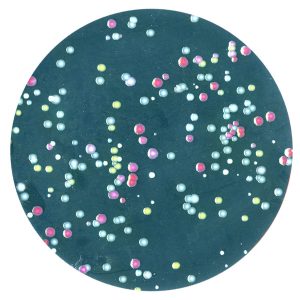

مقالات
النهج الفيزيائي بعلم الأحياء

مصر : إيهاب محمد زايد
يقدم نهج الفيزيائي في علم الأحياء رؤى بيئية. يختبر الفيزيائي جيف جور نظريات حول مجتمعات الميكروبات بشكل تجريبي ويوجد قواعد جديدة تحكم الاستقرار البيئي. جيف جور من معهد ماساتشوستس للتكنولوجيا عالم فيزياء من خلال التدريب ، لكنه يجلب الممارسات التجريبية الصارمة في هذا المجال إلى بحثه في المبادئ التي توجه ديناميكيات الإيكولوجيا الدقيقة.
في العام الماضي ، سار جيف جور في ممر قصير من مكتبه إلى مختبره في أحد مباني الجامعة في ميدان التكنولوجيا في كامبريدج ، ماساتشوستس. كانت الآلات تتأرجح ، ورائحة الكلور الخافتة قدمت تأكيدًا على أن الأشياء يتم تعقيمها بشكل صحيح. كانت عدادات المختبر مليئة بالماصات وألواح بلاستيكية بحجم الهاتف الذكي تقريبًا تحتوي على 96 بئراً شبه كروية ، قطر كل منها حوالي نصف سنتيمتر ، في شبكات 8 × 12. التقط جور صفيحة واحدة. قال “هذا مثل عالمنا”.
يقضي أعضاء مختبر جور في معهد ماساتشوستس للتكنولوجيا أيامهم في إنشاء ودس وحث جزر معزولة من البكتيريا وحيدة الخلية أو الخميرة التي تعيش في كل من تلك الآبار. يتم تحريض الأنواع ضد بعضها البعض أو تتعرض للحرارة أو البرودة أو نقص الغذاء. طوال الوقت ، كانت الأجهزة التي تسمى أجهزة قياس السيتومتر تقرأ نتائج تلك الآلاف من التجارب ، جيدًا ، وأحيانًا حتى خلية تلو الأخرى. بالنسبة إلى جور ، فإن القدرة على تحديد النتائج بدقة هي المفتاح. قال “يمكنك حقاً عد الخلايا”.
البيئة المحيطة وموضوعات البحث تليق بعلم الأحياء. ولكن من خلال التدريب وتحديد الهوية الذاتية ، يعتبر جور فيزيائيًا. ومع الجرأة التي تجعل الفيزيائيين محترمين وفي بعض الأحيان مستائين عندما ينتهكون مجالات أخرى ، فإن هذا الفيزيائي سريع الحديث والمتفائل على الدوام قد أجرى على مدى العقد الماضي ما يأمل أن يكون غزوًا مفيدًا للبيئة.
بنى جور مهنة بحثية حول التلاعب بالنظم البيئية المجردة من الميكروبات بحثًا عن أنواع المبادئ الأساسية العالمية التي صنعها الفيزيائيون بطاقة الاتصال الخاصة بهم عندما يتعلق الأمر بالعالم غير الحي ، والتي سعى علماء البيئة منذ فترة طويلة للحصول عليها. يقول زملاؤه إن ما يميز منهجه هو السعي وراء التجارب القابلة للتكرار والتحليل الإحصائي الذي ربما اعتبره علماء البيئة تقليديًا غير طبيعي ومضلل ، إن لم يكن بعيد المنال تمامًا.
لقد نجح هذا النهج ربما أكثر مما كان له أي حق. اكتشف جور القواعد التي تسمح له بعمل تنبؤات حول النظم البيئية الدقيقة البسيطة ، بما في ذلك الكائنات الدقيقة في الأمعاء لديدان المختبر والمجتمعات البكتيرية في عينات التربة. حتى علماء الأحياء وعلماء البيئة الذين قد يميلون إلى عدم الثقة في عالم فيزيائي دخيل يمتدحون موقف جور المحترم تجاه مجالهم ويقولون إنه يحرز تقدمًا حقيقيًا في المشكلات التي لطالما أربكتهم وزملائهم.
قال ستيفانو أليسينا ، عالم البيئة النظرية بجامعة شيكاغو ، إن آل جور “يمكنه طرح أسئلة عميقة حقًا حيث خدش الناس رؤوسهم لعقود”. “يمكنه تقطيع النظرية إلى تجربة جميلة حيث يمكنك الحصول على إشارة نظيفة وبيانات نظيفة.”
الآن يندفع جور نحو منطقة جديدة. بعد أن أتقن التلاعب بالميكروبات في المختبر ، يأمل في اكتشاف القواعد التي تحكم النظم البيئية في العالم الحقيقي التي يهتم بها الناس بالفعل. يمكن أن يساعد فهم كيفية تجمع الأنواع واستمرارها في المجتمعات الأطباء في علاج أمراض الأمعاء ، وتمكين المهندسين الزراعيين من هندسة تربة أكثر صحة ، ومساعدة دعاة الحفاظ على البيئة في حماية النظم البيئية أو ترميمها.
لكن الزملاء من كلا جانبي الفيزياء والبيولوجيا ، بينما يدعمون هذا الجهد ، يتساءلون كيف ستنجح استراتيجية جور التجريبية الصارمة جذريًا عند مواجهة التعقيد الكامل للعالم الحي.
عند التفكير في أعمق الأسئلة في مجالهم ، قد يسأل الفيزيائيون: لماذا يوجد شيء بدلاً من لا شيء؟ كثيرًا ما يسأل علماء البيئة: لماذا توجد أنواع كثيرة بدلًا من عدد قليل؟
أطلق عليها عالم البيئة الأسطوري ج.إيفلين هاتشينسون مفارقة العوالق ، لكن كان بإمكانه أيضًا أن يطلق عليها مفارقة البراري ، أو مفارقة الغابة المطيرة أو مفارقة ميكروبيوم الأمعاء. عمليًا في كل مكان تنظر إليه ، تختار الطبيعة التعقيد على البساطة ، وتتنوع على الزراعات الأحادية. العالم مليء بالأنواع ، لكن ليس من الواضح سبب ذلك: في أي بيئة معينة ، لماذا لا يوجد نوع واحد (أو على الأكثرعدد قليل) الحصول على ميزة وتفوق على البقية؟ أثارت هذه المشكلة حفيظة العلماء لأكثر من 150 عامًا ، منذ أن فكر داروين الشهير في فكرة “البنك المتشابك” في أصل الأنواع.
يمكن للباحثين تنمية مجتمعات الميكروبات على أطباق الاستزراع لمراقبة استقرار وتنافسية الأنواع (على اليسار). يختبر جور وزملاؤه نتائج مجموعات مختلفة من الميكروبات بشكل صارم ومنهجي في لوحة مزرعة بها 96 بئراً (على اليمين) لتحديد قواعد نتائج عمليات التزاوج المختلفة.
في عشرينيات القرن الماضي ، كتب عالما الأحياء الرياضي ألفريد لوتكا وفيتو فولتيرا بشكل مستقل أزواجًا من المعادلات المزدوجة لشرح كيف يمكن أن يتسبب نوع مفترس وفريسته في تذبذب أعداد بعضهما البعض بشكل ثابت بدلاً من الانفجار أو الانهيار ، مما يوفر دعمًا نظريًا للتعايش في نظام بيئي بسيط . لكن النظم البيئية الأكثر تعقيدًا تحدت مثل هذه العلاجات الرياضية النظيفة.
مع نضوج البيئة إلى تخصص متميز ، أنتج عمل هاتشينسون وآخرون فكرة أكثر جودة تسمى النظرية المتخصصة. مفهومها العام هو أن الأنواع تزدهر من خلال كونها الأفضل في الاستفادة من مجموعة معينة من الظروف البيئية – تفضل بعض الأشجار المواقع الباردة والرطبة بينما يعمل البعض الآخر بشكل أفضل في المناطق الحارة والجافة ؛ المجموعة الثالثة تنبت فقط بعد الحريق ، وهكذا. وبالتالي ، فإن عدم تجانس الطبيعة يخلق مساحات لإغراق الكائنات الحية.
منذ حوالي 20 عامًا ، تم تحدي هيمنة النظرية المتخصصة من خلال النظرية المحايدة ، التي افترضت أن الاختلافات بين الأنواع لا تهم عمومًا من الناحية البيئية لأن الانتواع والانقراض وموت الأفراد أكثر عشوائية مما يُفترض عادةً ، وأن العشوائية تمنع أي نوع من الهرب. تهيمن على منافسيها. لا يزال الجدل محتدماً حتى يومنا هذا – على الرغم من أن القليل من علماء البيئة يرفضون تمامًا المفهوم المتخصص.
مصدر الإحباط لعلماء البيئة النظريين هو أنه مع وجود الآلاف من النظم البيئية المتباينة حول العالم ، قد يكون من الصعب تزوير النظريات البيئية عالميًا. تمزح أليسينا قائلة إن كتب الفيزياء تبقى بنفس الطول تقريبًا بمرور الوقت لأن التجارب والملاحظات تزيف النظريات القديمة في نفس الوقت الذي تحفز فيه على نظريات جديدة. لكن نصوص البيئة تنمو لفترة أطول ، لأن النظريات القديمة تظل قائمة حتى مع تراكم نظريات جديدة. من غير الواضح ما إذا كانت المبادئ الموحدة التي تدعم علم البيئة – المكافئ للديناميكا الحرارية والميكانيكا الإحصائية في الفيزياء – غير معروفة لأنه لم يكتشفها أحد بعد أو لأن هذه المبادئ ببساطة غير موجودة.
اختبار النظريات الكبيرة الجميلة
دخل جور ، الذي لا يهدأ جسديًا وفكريًا ، في الصراع البيئي بعد أن غمس أصابع قدميه في العديد من البرك العلمية الأخرى. عندما كان طالبًا جامعيًا في معهد ماساتشوستس للتكنولوجيا في أواخر التسعينيات ، ساعد في تطوير جهاز تجريبي لدراسة مكثفات بوز-آينشتاين مع وولفجانج كيتيرل ، الذي فاز بجائزة نوبل في عام 2001 لكونه من بين أول من أنتج تلك المادة الخامسة التي ظلت نظرية طويلة المدى. حالة المادة. في كلية الدراسات العليا بجامعة كاليفورنيا ، بيركلي ، هاجر جور إلى الفيزياء الحيوية ، باحثًا عن الآليات المعقدة لجزيء الحمض النووي. عاد إلى معهد ماساتشوستس للتكنولوجيا كباحث ما بعد الدكتوراة ، وهذه المرة تجاوز حدود الفيزياء الحيوية التقليدية ، مستخدمًا الخميرة لاستكشاف تطور السلوك التعاوني تجريبيًا.
بمرور الوقت ، تم إغراء جور بما يسميه “النظريات الكبيرة والجميلة” في علم البيئة لكيفية تواجد الكائنات الحية في المجتمعات المعقدة. لكنه لاحظ أيضًا أن “النظرية والقياسات لا تُثري بعضهما البعض دائمًا بقدر ما تستطيع”. لقد رأى فتحة لقياسات واضحة لا لبس فيها وقابلة للتكرار يمكن أن تختبر الفرضيات بدقة وربما تقضي على التراكم النظري الذي تندب عليه أليسينا. بالنسبة إلى جور ، كان هذا يعني ممارسة مستوى من التحكم في الطبيعة قد يجده العديد من علماء الأحياء مصطنعًا إلى أقصى الحدود. بدأ في وضع الميكروبات في أماكن محكومة بإحكام واستخدام أدوات متطورة لتتبع مصير الأفراد بدقة. هذا ، حسب رأيه ، سيسمح له بضبط بعض ضجيج وفوضى الطبيعة حتى يتمكن من تكرار التجارب عدة مرات وتوليد أنواع الإحصائيات التي تقنع الفيزيائيين بأنهم سمّروا ظاهرة.
عرض مكبّر للبكتيريا التي تنمو على طبق أجار.
كل نقطة على هذا المنظر المكبر للوحة أجار هي مستعمرة مميزة من البكتيريا. من خلال عدهم ، يمكن للباحثين تحديد تكوين الأنواع في المجتمع الميكروبي. قال كيريل كوروليف ، عالم فيزيائي سيست الذي أجرى بحثًا في مختبر جور ويدير الآن أبحاثه الخاصة في جامعة بوسطن. “تفقد التعقيد ، ولكن هناك أيضًا فوائد.”
بدأ جور بأبسط نظام بيئي ممكن: نوع واحد فقط. حتى هذا ، كما اتضح ، يمكن أن يكون ممتعًا. صمم جور وأعضاء معمله ، بما في ذلك كوروليف ، تجربة قاموا فيها بتخفيف مستعمرات خميرة البيرة التي تنمو في محاليل السكر. تقوم خلايا خميرة بروير بتحويل السكريات غير الصالحة للأكل إلى سكر صالح للأكل ، لذلك يستفيد الأفراد من وجود العديد من الجيران القريبين ، بينما يؤدي التخفيف إلى تجويع تعداد الخميرة. حدد الباحثون إشارات في بياناتهم تسمح لهم بالتنبؤ بما إذا كانت مجموعات الخميرة ستزدهر أو تنهار. تضمنت الدراسة ، التي نُشرت في عام 2012 في مجلة Science والأكثر اقتباسًا من معمل جور حتى الآن ، رقمًا يُعرف باسم مخطط التشعب ، والذي يرسم خرائط للظروف الدقيقة التي يظل النظام البيئي فيها مستقرًا أو يمر بنقطة تحول كارثية.
قالت أليسينا إن مثل هذا المخطط “شيء عزيز جدًا على معظم علماء البيئة الرياضيين”. ساعد الراحل روبرت ماي ، الفيزيائي الرائد الذي تحول إلى عالم البيئة ، في إطلاق مجال نظرية الفوضى عندما اكتشف أن المعادلة المستخدمة لنمذجة النمو السكاني للحشرات أنتجت مخططًا للتشعب. أخذ فريق جور الفكرة من الكمبيوتر والسبورة إلى المختبر.
قالت أليسينا: “كانت تلك الورقة مذهلة للغاية”. “تظهر البيانات أنها تعمل تمامًا كما تتوقع النظرية. كان هذا هو الشيء الذي جعلني مدركًا جدًا لعمل [جور] “.هناك مزحة مفادها أن علماء الفيزياء يمكنهم وصف أنظمة مكونة من عنصر واحد أو عنصرين أو عناصر فردية لا نهائية ، ولكن لا شيء بينهما. بعد أن أثبت قدرته على توليد رؤى من نوع واحد ، انتقل جور إلى نوعين. في العمل الذي قاده جوناثان فريدمان بعد الدكتوراة ، عزل أعضاء مختبر جور ثماني سلالات بكتيرية من التربة ووضعوها ضد بعضها البعض في مجموعات مختلفة في أطباقهم المكونة من 96 بئراً. من النتائج ، وضع الباحثون مجموعة من القواعد البسيطة: يمكن أن يتعايش A يتفوق B و B على المنافسين C و C و D ، وهكذا.
كان باحثًا في مرحلة ما بعد الدكتوراة في مختبر جور ، فقد قاد التجارب التي حددت النتائج الزوجية لثماني سلالات بكتيرية مشتركة في السكن.
ثم قام العلماء بخلط الأنواع في ثلاثيات. وجد فريق Gore أن نتائج المعارك الفردية سمحت لهم بالتنبؤ بدقة 90٪ بما إذا كان نوع معين سينجو في الخلطات الأكثر تعقيدًا. بعبارة أخرى ، إذا فاز A على B ، و B تغلب على C ، فمن شبه المؤكد أن A سيهزم B و C.
ومع ذلك ، فإن ثمانية ميكروبات بالكاد تثبت أنها نقطة عالمية. لذلك اتخذ الباحثون خطوة أخرى نحو العالم الحقيقي: ذهب طالب الدراسات العليا لوجان هيغينز إلى حديقة ميدان التكنولوجيا في معهد ماساتشوستس للتكنولوجيا وجرف بعض التربة المليئة بالميكروبات. عزل الفريق السلالات وحدد القواعد الزوجية التي تحكم قدرات الميكروبات على التنافس أو التعايش مع بعضها البعض. درس الباحثون بعد ذلك ما يقرب من ألف ثلاثي بكتيري في آبارهم البلاستيكية.
كانت هذه التجارب مدفوعة جزئياً باقتراحات تعود إلى سبعينيات القرن الماضي مفادها أن مزيجًا من العديد من الأنواع قد يثبت بعضها البعض من خلال التوازن التنافسي. أحد الأمثلة على مثل هذا التفاعل المثبِّت “عالي الرتبة” يشبه لعبة مقص ورق الصخر ، حيث يقوم كل نوع من الأنواع الثلاثة المتعايشة بقمع أحد المنافسين ولكن يتم قمعه من قبل الآخر. اقترح المنظرون أن مثل هذه الترتيبات يمكن أن تكون طريقة أنيقة لتوليد أنظمة بيئية متنوعة من خلال منع أي نوع من التنافس على الباقي. تم تصميم الثلاثيات البكتيرية التي استقرت من خلال العلاقات بين الصخور والورق والمقص في المختبر.
لكن ندرة البيانات التجريبية جعلت من الصعب معرفة مدى أهمية هذا الترتيب في البرية. قالت أليسينا: “أحب مقص ورق الصخر”. “هذا لا يجعلها شائعة جدًا في الطبيعة.”
من بين سلالات التربة ، وجد فريق جور علاقة واحدة فقط بين الصخر والورق والمقص. كما في التجربة السابقة ، يبدو أن نتائج المعارك الفردية تحكم النظام البيئي العام ؛ في حالة واحدة فقط ، تغلبت البكتيريا C على A لإكمال المثلث. عندما ألقى الباحثون 20 سلالة في الآبار معًا ، ظهرت ثلاث سلالات فقط على أنها مهيمنة ، كما تنبأت القواعد الزوجية – وهي بعيدة كل البعد عن مجتمع التربة الأصلي المتنوع والمستقر. مع استبعاد مقص ورق الصخر بالكامل تقريبًا ، خلص فريق جور إلى أن التحولات الطفيفة في الظروف البيئية داخل المصفوفة الفيزيائية للتربة ربما أدت إلى استقرار المجتمع المتنوع في بيئته الطبيعية ، لأن العلاقات بين ثلاثة أو أكثر من الميكروبات لا يبدو أنها تؤدي المهمة. في المختبر.
أشارت الدراسات إلى أن أساليب جور يمكن أن يكون لها ما تقوله عن الأرض اللامتناهية بين اثنين وما لا نهاية التي تحتلها النظم البيئية في العالم الحقيقي. “لا أعتقد أن ما نجده يعني بالضرورة أن هذه هي الطريقة التي يعمل بها أي نظام بيئي ، “قال فريدمان ، وهو الآن محاضر كبير في الجامعة العبرية في القدس في رحوفوت ، إسرائيل. “لكنه أفضل جهد لمعرفة كيفية عمل نظام بيئي واحد.”
قال جور: “نحن حقًا نبني … على غرار الطريقة التي فهم بها الفيزيائيون ميكانيكا الكم والذرات”. حاولنا أولاً أن نفهم الهيدروجين. ليس الأمر أن الفيزيائيين كانوا مهووسين بالهيدروجين في حد ذاته ، ولكن إذا لم تفهم الهيدروجين ، فمن الخطير بعض الشيء أن تحاول المبالغة في ذلك. … هذه هي الطريقة التي أرى بها نهجنا. بدأنا بالهيدروجين ، ونحن نوعا ما في الهيليوم والميثان الآن “.
الميكروبات حيوية للطبيعة. تحافظ بكتيريا التربة وفطرياتها على النباتات التي نأكلها والغابات التي توفر استقرار المناخ ومعظم التنوع البيولوجي للأرض. تساعدنا البكتيريا في أحشائنا على هضم الطعام ويعتقد أنها تساهم في المناعة وربما حتى الإدراك. لكن المجتمعات الميكروبية يمكن أن تسبب الدمار أيضًا. ربما يكون أفضل مثال معروف يحدث عندما تغزو بكتيريا المطثية العسيرة الأمعاء ، مسببة التهاب القولون المؤلم والمميت في بعض الأحيان. مثل هذه الغزوات يصعب التنبؤ بها ويصعب عكسها. اليوم ، يتم علاجهم بشكل متزايد عن طريق زرع البراز – محاولة القوة الغاشمة لاستبدال ميكروبيوم غير صحي بآخر صحي.
قالت أليسينا: “نحن لا نفهم أي شيء ، لذلك نقوم بزرع المجتمع بأكمله وعبر أصابعنا”. “هل تعتقد حقًا أنك بحاجة إلى كل 5000 سلالة؟ … على الاغلب لا. ربما يكون للمجتمعات الأصغر التي لديها عدد قليل من الأشياء نفس النتيجة “.
مدعومًا بسلسلة نتائجه الواعدة ، وضع جور نصب عينيه مؤخرًا على ميكروبيوم الأمعاء. في دراسة نُشرت في فبراير ، وجد فريقه أنه عندما تم غزو نظام بيئي مكون من ميكروبين لفترة وجيزة من قبل نوع ثالث ، فإن السلالة السائدة في النظام البيئي غالبًا ما تتغير. اقترح المؤلفون أن ديناميكية مماثلة يمكن أن تلعب دورًا في عدوى المطثية العسيرة.
يناقش الفيزيائي جيف جور من معهد ماساتشوستس للتكنولوجيا لغز التنوع الكبير في النظم البيئية ، وكيف أثرت خلفيته في الفيزياء على نهجه التجريبي لدراسة علم البيئة.
فيديو: يناقش الفيزيائي جيف جور من معهد ماساتشوستس للتكنولوجيا لغز التنوع الكبير في النظم البيئية ، وكيف أثرت خلفيته في الفيزياء على نهجه التجريبي لدراسة البيئة.
ولكن في محاولة لاستخلاص قواعد تجميع الأنواع العالمية من مستنقع الأمعاء البشرية ، يواجه جور صعودًا شاقًا في التعقيد. في أحشائنا ، أكثر من تريليون بكتيريا تتكون من مئات الأنواع تتنافس وتتعايش في وقت واحد. فتح الطريق نحو التقدم عندما أحضر باحث ما بعد الدكتوراة الجديد ، نيك فيغا ، دودة إلى مختبر جور: Caenorhabditis elegans ، وهو كائن حي نموذجي درسه آلاف علماء الأحياء. الدودة ، مثلنا ، لديها أمعاء وميكروبيوم ، لكن هذا الميكروبيوم يحتوي على 100000 عضو فقط أو نحو ذلك.
من خلال تكييف النهج من تجارب التربة ، قام Vega بإطعام أزواج من الديدان من البكتيريا ذات العلامات الحمراء والخضراء ، والسماح للبكتيريا بالتخلص منها داخل الأمعاء ، ثم قم بتثبيت الديدان لتحديد مقدار بقاء كل نوع. لقد حددوا أن التقلبات العشوائية في معدلات استعمار النوعين البكتيريين للديدان أدت إلى اختلافات كبيرة في الميكروبيومات المجمعة بالكامل للديدان. قال فيجا إن فكرة إمكانية تفسير مثل هذه الاختلافات كانت “غريبة بعض الشيء” بالنسبة لباحثي الميكروبيوم.
كان رأي جيف في هذا هو: لنأخذ أبسط شيء ، ودعونا نرى كيف يمكننا قياس هذا الشيء الأكثر بساطة. تفقد التعقيد ، ولكن هناك أيضًا فوائد.
في دراسة متابعة ، درس فيغا وطالب الدراسات العليا أنتوني أورتيز لوبيز نتائج المسابقات الزوجية بين 11 نوعًا من البكتيريا التي تعيش في أحشاء الديدان ، ثم قاما بتغذية خليط من الديدان يصل إلى ثلاثة من هذه الأنواع. كما هو الحال في التربة ، توقعت القواعد الزوجية إلى حد كبير النتيجة النهائية في معظم الحالات. نشر الباحثون ورقة أولية على خادم ما قبل الطباعة biorxiv.org وقدموها إلى مجلة لمراجعتها من قبل الزملاء.
قال جور إن التجربة أظهرت أنه على الرغم من أهمية العوامل الخارجية ، فإن “النتائج الزوجية هي أشياء قوية” للتنبؤ بتطور المجتمعات الميكروبية في مجموعة من البيئات.
وبالمثل ، بالنسبة لفيغا ، الأستاذ الآن في جامعة إيموري في أتلانتا ، تمثل النتيجة إثباتًا قويًا على أن أساليب جور تترجم إلى كائنات حية في العالم الحقيقي. قال فيجا: “بالتأكيد في النظام البيئي للأمعاء البشرية ، ليس من الممكن فعليًا القيام بجميع التفاعلات الزوجية للميكروبات الموجودة”. “ما نحاول اكتشافه الآن هو … ما هي المعلومات التي تحتاجها بالفعل للتنبؤ بالسلوك ، وما هي أفضل طريقة للحصول عليها؟” ما شاهده فيجا حتى الآن يجعلهم متفائلين. “لدي أمل في أن نكون قادرين على فهم خصائص ميكروبيوم الثدييات ، وإعادة هندسة الميكروبيوم في الثدييات عمدًا.”
لم يقتنع الجميع بهذا. إلى جانب الصعوبات التي تسببها أعدادهم وتنوعهم الهائل ، تفرز البكتيريا باستمرار مركبات تغير البيئة بالنسبة لهم ولكل شيء من حولهم. سيتطلب التقاط مثل هذه الفروق الدقيقة إنجازات تتجاوز ما حققه جور أو أي شخص آخر.
قال تامي ليبرمان ، عالم الأحياء في معهد ماساتشوستس للتكنولوجيا الذي يدرس العلاجات القائمة على الميكروبيوم: “أعتقد أنه سيكون من الصعب جدًا تكرار الميكروبات البشرية بالكامل في المختبر”. لكنها تؤكد أن هذا لا يعني أن الأمر لا يستحق الجهد المبذول. في الواقع ، كبداية في هذا الاتجاه ، يناقش ليبرمان وجور تجربة تعاونية لاختبار مدى نجاح القواعد الزوجية في التنبؤ بالتفاعلات الميكروبية في الأمعاء البشرية.
بالنسبة إلى بانكاج ميهتا ، عالم الفيزياء النظرية بجامعة بوسطن ، على الجانب الآخر من نهر تشارلز مباشرةً من معهد ماساتشوستس للتكنولوجيا ، تجاوز نهج جور التوقعات. في وقت مبكر ، اعتقد ميهتا أن جور كان يتجاهل تفاصيل مهمة حول البيئات الميكروبية ، لكن ميهتا اعترف بأن هذه التفاصيل أثبتت أنها أقل أهمية مما كان يعتقد. قال ميهتا: “المثير للاهتمام والمثير للإعجاب في العمل هو أنهم أظهروا أن العديد والعديد من الظواهر المختلفة – تغيرات الأس الهيدروجيني ، والتنافس على العناصر الغذائية – يمكن التقاطها جميعًا باستخدام هذه النماذج الظاهراتية البسيطة ، على الأقل في الأنظمة التي يوجد بها عدد قليل من الأنواع” . “هذا اختزال حقيقي ومُجرب من النوع الذي يخدم جيدًا في الفيزياء.”
يحترم بانكاج ميهتا ، الفيزيائي النظري بجامعة بوسطن الذي يدرس المجتمعات الميكروبية ، نهج جور “التصاعدي” ولكنه يشك في إمكانية العمل مع الإيكولوجيا الطبيعية المعقدة.
لكن ميهتا ، أيضًا ، لا يزال متشككًا بشأن المدى الذي يمكن أن يذهب إليه جور. يقدم تشبيهًا: عندما يحاول الفيزيائيون وصف 1023 جزيءًا من الهواء قد تدور حول غرفة في أي لحظة ، فإنهم لا يكتبون معادلة لكل جزيء. بدلاً من ذلك ، يبحثون عن معلمات تصف متوسط سلوك الجسيمات – ومن هنا جاء اللانهاية في نكتة “واحد ، اثنان ، وما لا نهاية”. بالنسبة للغاز ، اتضح وجود مثل هذه المعلمة: درجة الحرارة. انظر إلى مقياس حرارة ، وستعرف الكثير مما يستحق معرفته عن أي عدد كبير بما فيه الكفاية من الجزيئات من حولك.
يعتقد ميهتا أن هذا النهج “التنازلي” يمكن أن ينجح أيضًا مع الميكروبات. في الدراسات التي أجرتها مجموعته وآخرون ، استطاعت المعلمات عالية المستوى مثل توافر العناصر الغذائية ودرجة اعتماد الأنواع البكتيرية على إفرازات بعضها البعض ، الحصول على معلومات مهمة حول كيفية عمل المجتمعات الميكروبية ، دون الحاجة إلى معرفة مفصلة بأعضاء تلك المجتمعات. أو التفاعلات.
يقول ميهتا إن جور يحاول بفاعلية حساب كل ميكروب ، في ما يسميه العلماء نهج “من أسفل إلى أعلى”. قال ميهتا ، بينما نجح ذلك بشكل جيد حتى الآن ، “أعتقد أنه سيكون بلا شك أكثر صعوبة لإيجاد طريقة لأنظمة معقدة للغاية”. “أعتقد بالتأكيد أنه سيصبح أقل تنبؤية.”
كما تفضل أليسينا ، في عمله الخاص ، النهج التنازلي. في دراسة النمذجة لعام 2018 ، ألقى 100 ميكروب محاكى معًا ووجد أن النظم البيئية المستقرة تشكلت بغض النظر عن خصائص التفاعلات بين الميكروبات. لكن أليسينا تعتقد أن كلا الاستراتيجيتين ضروريان. قالت أليسينا: “أنا أحب القمة … إنها أكثر متعة”. “لكنني أعتقد أن الإجابة ستكون في المنتصف.”
يشير عالم البيئة النظري في جامعة برينستون ، سيمون ليفين ، إلى تحدٍ آخر يجب على جور مواجهته: الميكروبات ، على عكس العناصر الكيميائية أو الجسيمات دون الذرية ، تتطور باستمرار ، لذلك يتغير نظام الدراسة أثناء تجربتها. قال ليفين: “سيكون هذا دائمًا تقييدًا لأي نوع من النظرية التنبؤية” في علم الأحياء. “عندما يأتي شيء ما من الحقل الأيسر ، يكون من الصعب جدًا بناء نظرية لما يمكن أن يكون.”
قد تظهر السنوات القليلة المقبلة ما إذا كان بإمكان جور تحقيق الأهداف السامية التي حددها لنفسه. ووفقًا لطبيعته المضطربة الساعية إلى التحسين ، فقد أصبح مؤخرًا متحمسًا للتعاون مع فريدمان وبول بلايني من معهد برود الذي يعيد استخدام شريحة نانوفلويديكس التي صممها بلايني لفحص الأدوية عالي الإنتاجية. استخدم الباحثون الشريحة مؤخرًا لدراسة أكثر من 180 ألف تفاعل بين 20 بكتيريا تربة في 40 بيئة مختلفة ووجدوا أن التفاعلات التي يستفيد فيها ميكروب واحد من وجود ميكروب آخر أكثر شيوعًا مما كان متوقعًا – وهي نتيجة يمكن أن تكون ضربة أخرى للتقليدية. حكمة حول كيفية تصرف البكتيريا في المجتمعات.
يقول ليفين إن غور زاد من احتمالات نجاحه بفعل شيء واحد مهم بشكل صحيح. قال ليفين: “إنه لا يأتي كما يفعل الكثير من الفيزيائيين ويقول ،” أنا فيزيائي وأنا هنا لمساعدتك “. “لقد حول جيف نفسه إلى عالم أحياء. يظهر احتراما لأفكار المجال “.